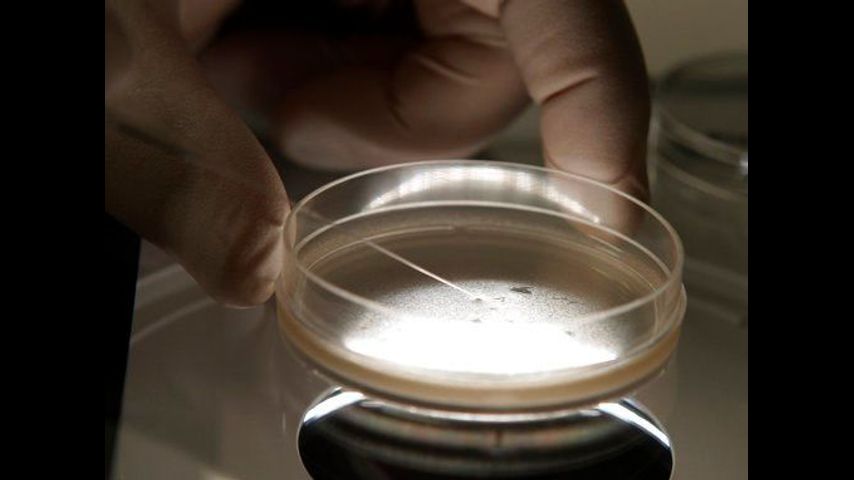

Stem cell shots linked to bacterial infection outbreak
By MIKE STOBBE
AP Medical Writer
NEW YORK (AP) - Health officials on Thursday reported an outbreak of bacterial infections in people who got injections of stems cells derived from umbilical cord blood.
At least 12 patients in three states - Florida, Texas and Arizona - became infected after getting injections for problems like joint and back pain, the Centers for Disease Control and Prevention said. All 12 were hospitalized, three of them for a month or longer. None died.
Investigators don't think the contamination occurred at the clinics where the shots were given, because they found bacteria in unopened vials provided by the distributor, Yorba Linda, California-based Liveyon.
Liveyon voluntarily recalled the stem cells in October.
Last month, the Food and Drug Administration sent a warning to Genetech Inc., the small San Diego company that processed the stem cells. The FDA said the company should not be marketing the stem cells without regulators' approval and has deviated from manufacturing requirements in ways that could have led to bacterial contamination.
Stem cells are very young cells than can develop into specialized cells, like blood cells, bone cells and brain cells. The cells are being studied as a potential way to treat many diseases and are currently approved for a handful of medical procedures. In recent years, hundreds of private clinics have opened promoting their use for diseases in which there is little evidence they are safe or effective.
Stem cells can be harvested from adults, but another source is umbilical cord blood, which can be collected at the time of birth, stored and later used as a treatment for the child or family members who develop conditions like blood or immune disorders. Officials say stems cells from cord blood also are being sold to doctors to treat patients for conditions like pain in their joints, shoulders or back.
Last year, the FDA announced plans to crack down in doctors and businesses promoting stem cell injections for diseases ranging from arthritis to Alzheimer's disease.
The CDC reported that stem cells from cord blood were the source of bacterial infections in seven in Texas, four in Florida and one in Arizona. The average age of the patients was 74.
Five different germs were seen in the patients, including one type of E. coli.
"These are not organisms you want in your bloodstream or joint space," said Dr. Kiran Perkins, the CDC medical officer leading the agency's investigation.
___
The Associated Press Health & Science Department receives support from the Howard Hughes Medical Institute's Department of Science Education. The AP is solely responsible for all content.
Copyright 2018 The Associated Press. All rights reserved. This material may not be published, broadcast, rewritten or redistributed.